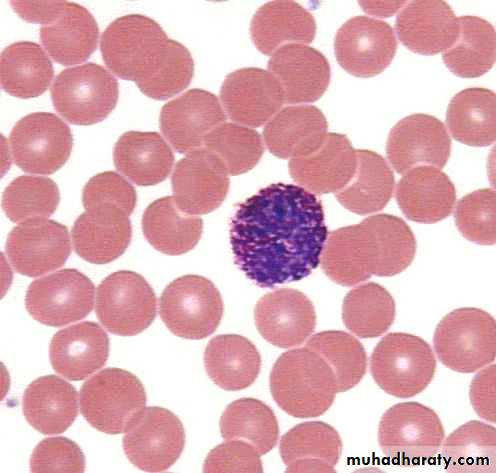
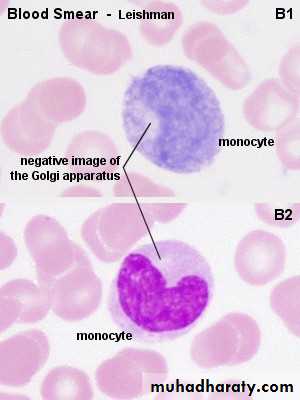
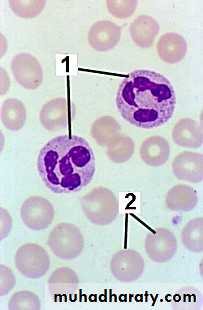
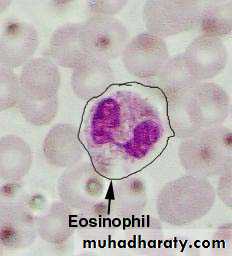
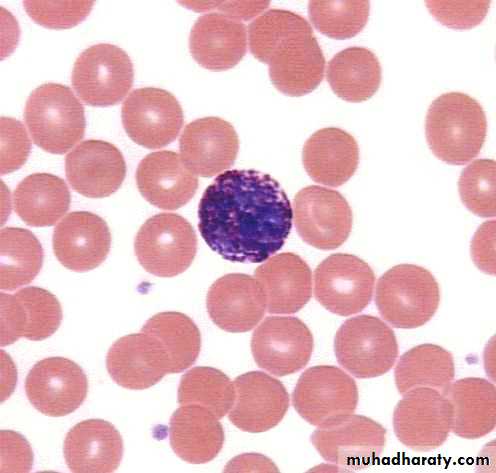
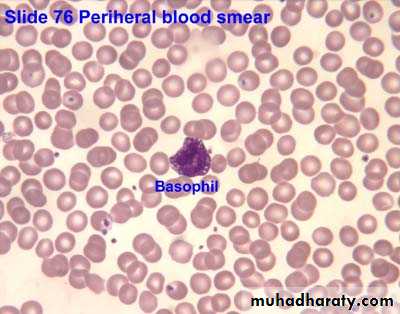
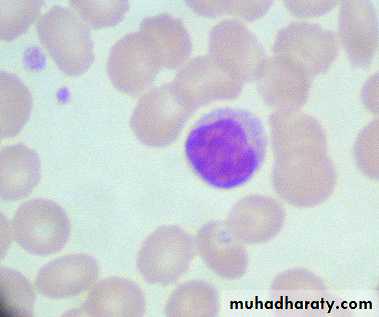

The Cardiovascular System: The Blood
University of IshikFaculty of Dentistry
Abdulqadir Khdir Hamad
M.Sc. Medical BiologyAbdulqadir.bio@raparinuni.org
Lec. Physiology
White Blood Cells/ Leukocytes
Protect body against microorganisms, foreign invaders and remove dead cells and debrisContain nuclei with DNA, the shape depends on type of cell
Life span is from 24 hours to several years
Size is 8-20 micrometers in diameter
Granular or agranular based on staining highlighting large conspicuous granules
Granular leukocytes
Neutrophils, eosinophils, basophils
Agranular leukocytes
Lymphocytes and monocytes
Granulocytes
AgranulocytesFunctions of the Immune System
To protect the entire body from a variety of harmful substancespathogenic microorganisms
allergens
toxins
malignant cells
Functions of WBCs
Usually live a few daysExcept for lymphocytes – live for months or years
less numerous than RBCsGeneral function to combat invaders by phagocytosis or immune responses
WBC’s
Classified according to the presence or absence of granules and the staining characteristics of their cytoplasm.
Leukocytes appear brightly colored in stained preparations, they have a nuclei and are generally larger in size than RBC’s.
Type of WBC’s
Granulocytes—have large granules in their cytoplasmNeutrophils
EosinophilsBasophils
Types of WBC’s
Agranulocytes—do not have granules in their cytoplasmLymphocytes
MonocytesGranuloctyes
NeutrophilsStain light purple with neutral dyes
Granules are small and numerous—course appearance
Several lobes in nucleus
Diapedesis—Can leave blood vessels and enter tissue space
Phagocytosis (eater), contain several lysosomes (janitor)
Granulocytes
EosinophilsLarge, numerous granules
Nuclei with two lobes
2-5% of WBC count
Found in lining of respiratory and digestive tracts
Important functions involve protections against infections caused by parasitic worms and involvement in allergic reactions
Secrete anti-inflammatory substances in allergic reactions
Play roles in ending allergic reactions
Granulocytes
BasophilsBasophils – about 0.5% of all leukocytes
Nucleus – usually two lobes
Granules secrete histamines
Function in inflammation mediation,
Diapedesis—Can leave blood vessels and enter tissue space
Contain histamine—inflammatory chemical
Agranulocytes
LymphocytesSmallest WBC
Large nuclei/small amount of cytoplasm
The most important cells of the immune system
Effective in fighting infectious organisms
Act against a specific foreign molecule (antigen)
Two types :
-T lymphocytes: attack an infect or cancerous cell
- B lymphocytes produce antibodies against specific antigens (foreign body)
Lymphocytes
Lymphocytes
T cells or T Lymphocytesmature in thymus gland
Cell mediated immunity
B cells or B Lymphocytes
mature in bone marrow
antibody-mediated immunity
T Cell or T Lymphocyte(Cell Mediated Immunity)
T Cell (cell mediated immunity)circulating lymphocytes
produced in bone marrow
matures in thymus
live for years
primary function: coordinate immune defenses and kill organisms
Lymphocyte: T Cells
helper T cells - essential to proper functioning of immune systemMemory cells- remember antigens and stimulate a faster response if same antigen introduced at a later time
Agranulocytes
Monocytes
Largest of WBCs
Monocytes – compose 4–8% of WBCs
Dark kidney bean shaped nuclei
Highly phagocytic
Transform into macrophages
macrophage - phagocytic cell that protects body by ingesting invading cells
Emigration of WBCs
Many WBCs leave the bloodstreamEmigration (formerly diapedesis)
Roll along endothelium
Stick to and then squeeze between endothelial cells
Precise signals vary for different types of WBCs
WBCs
Neutrophils and macrophages are active phagocytesAttracted by chemotaxis
Neutrophils respond most quickly to tissue damage by bacteria
Uses lysozymes, strong oxidants, defensins
Monocytes take longer to arrive but arrive in larger numbers and destroy more microbes
Enlarge and differentiate into macrophages
WBCs
Basophila leave capillaries and release granules containing heparin, histamine and serotonin, at sites of inflammationIntensify inflammatory reaction
Involved in hypersensitivity reactions (allergies)
Eosinophils leave capillaries and enter tissue fluid
Release histaminase, phagocytize antigen-antibody complexes and effective against certain parasitic worms
• Type Of White Blood Cells
• % By Volume Of WBC
• Description
• Function
• Neutrophils
• 60 – 70 %
• Nucleus has many interconnected lobes; blue granules
• Phagocytize and destory bacteria; most numerous WBC
• Eosinophils
• 2 – 4 %
• Nucleus has bilobed nuclei; red or yellow granules containing digestive enzymes
• Play a role in ending allergic reactions
• Basophils
• < 1 %
• Bilobed nuclei hidden by large purple granules full of chemical mediators of inflammation
• Function in inflammation medication; similar in function to mast cells
• Lymphocytes (B Cells and T Cells)
• 20 – 25 %
• Dense, purple staining, round nucleus; little cytoplasm
• the most important cells of the immune system; effective in fighting infectious organisms; act against a specific foreign molecule (antigen)
• Monocytes
• 4 – 8 %
• Largest leukocyte; kidney shaped nucleus
• Transform into macrophages; phagocytic cells
Lymphocytes
Lymphocytes are the major soldiers of the immune system
B cells – destroying bacteria and inactivating their toxins
T cells – attack viruses, fungi, transplanted cells, cancer cells and some bacteria
Natural Killer (NK) cells – attack a wide variety of infectious microbes and certain tumor cells
Platelets/ Thrombocytes
Myeloid stem cells develop eventually into a megakaryocyteEach fragment enclosed in a piece of plasma membrane
Disc-shaped with many vesicles but no nucleus
Help stop blood loss by forming platelet plug
Granules contain blood clot promoting chemicals
Short life span – 5-9 days